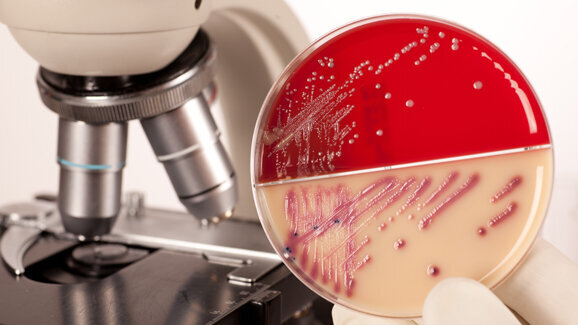
Antibakterielle ­Beschichtungen untersucht

SAARBRÜCKEN - Ob Frischhaltefolie an der Glasschüssel oder die Bakterien an der Kühlschrankwand, Haftung ist ein Alltagsphänomen. Im Falle der Bakterien kann dies jedoch gefährlich sein, zum Beispiel im Operationssaal, weshalb antibakterielle Beschichtungen ein wichtiges Forschungsthema sind.
Neuste Studienerkenntnisse zur Haftkraft von Bakterien zur Verbesserung medizinischer Implantate.
Physiker und Mikrobiologen der Universität des Saarlandes sind der Frage nachgegangen, welche Kräfte eigentlich die Haftung von Bakterien und von Proteinen bestimmen.
Die Wissenschaftsteams um Jacobs und Herrmann haben die Haftkraft von Bakterien an Oberflächen untersucht. Für die Versuche verwendeten sie sogenannte Silizium-Einkristallplättchen als Oberflächen. Auf diesen Plättchen befinden sich wiederum Schichten aus Siliziumoxid mit variabler Schichtdicke. Es zeigte sich, dass die Bakterien doppelt so stark haften, wenn sie das Silizium der Plättchen noch durch die dünne Oxidhaut hindurch „spüren“ können. Dies bedeutet gleichzeitig, dass – trotz identischer Zusammensetzung der letzten Atomlagen – die Bakterien spüren, was sich unterhalb der Oberfläche befindet. „Bei den Proteinen verhält es sich ähnlich“, erklärt Karin Jacobs. „Protein- und Bakterienadsorption sind wichtige Schritte bei der Biofilmbildung, daher sind die Ergebnisse für viele Bereiche interessant.“ Biofilme bilden sich immer da, wo Mikroorganismen auf eine sogenannte Grenzfläche treffen. „Da Biofilme häufig die Ursache von Entzündungen sind, zum Beispiel auf Implantaten oder Herzklappen, ist dies auch medizinisch höchst relevant“, so Herrmann. So können die Erkenntnisse dabei helfen, zum Beispiel antibakterielle Beschichtungen und medizinische Implantate zu verbessern.
Studie: Influence of the Subsurface Composition of a Material on the Adhesion of Staphylococci/ Peter Loskill, Hendrik Hähl, Nicolas Thewes, Christian Titus Kreis, Markus Bischoff, Mathias Herrmann, and Karin Jacobs, Department of Experimental Physics, Saarland University, Saarbrücken, 66041, DOI: 10.1021/la3004323
HALLE - Forscher der Martin-Luther-Universität Halle-Wittenberg (MLU) haben ein Verfahren entwickelt, um entzündungshemmende Stoffe auf die Implantate zu ...
BERLIN – Seit der Entdeckung des Potenzials der antibakteriellen Photodynamischen Therapie (aPDT) für die Behandlung bakterieller ...
WIEN – In der Zahnmedizin wurde er ursprünglich erkannt und ist nun Forschungsobjekt eines internationalen Forscherteams: der Kleber von ...
DÜBENDORF, SCHWEIZ – Mit einem Verband, der Medikamente freisetzt, sobald eine Infektion in einer Wunde beginnt, ließen sich Verletzungen ...
USA – Wer an Kaugummi denkt, hat meist frischen Atem im Kopf, vielleicht noch schnelle Zahnpflege zwischendurch. Dass ein Kaugummi gezielt in das ...
ATHEN, Griechenland – Der Schneider'schen Membran kommt in der heutigen Implantologie eine besondere Rolle zu. Griechische Forscher untersuchten, ob ...
DRESDEN – Ängsten und Phobien mit Vermeidungsstrategien zu begegnen, ist nicht ungewöhnlich. Im Fall der Zahnarztangst könnte sich dieses Verhalten ...
DORNBIRN – 25.000 Kinder wurden im Rahmen der Zahnprophylaxe untersucht – das Projekt steht beispielhaft für die Sinnhaftigkeit regionaler ...
Madrid – Implantologische Eingriffe sind nicht nur fachlich fordernd, sondern offenbar auch körperlich spürbar. Eine spanische Pilotstudie hat ...
AMSTERDAM, NIEDERLANDE – Küssen zählt nicht nur zu einer der schönsten Nebensachen der Welt – intime Lippenbekenntnisse ...
Live-Webinar
Di. 23. Juni 2026
2:00 Uhr (CET) Vienna
Live-Webinar
Di. 23. Juni 2026
19:00 Uhr (CET) Vienna
Live-Webinar
Di. 23. Juni 2026
21:00 Uhr (CET) Vienna
Live-Webinar
Mi. 24. Juni 2026
14:00 Uhr (CET) Vienna
Live-Webinar
Mi. 24. Juni 2026
17:00 Uhr (CET) Vienna
Live-Webinar
Mi. 24. Juni 2026
18:30 Uhr (CET) Vienna
Dr. med. dent. Britta Hahn
Live-Webinar
Do. 25. Juni 2026
20:00 Uhr (CET) Vienna
Dr. Hatem Algraffee, Cat Edney



 Österreich / Österreich
Österreich / Österreich
 Bosnien und Herzegowina / Босна и Херцеговина
Bosnien und Herzegowina / Босна и Херцеговина
 Bulgarien / България
Bulgarien / България
 Kroatien / Hrvatska
Kroatien / Hrvatska
 Tschechien & Slowakei / Česká republika & Slovensko
Tschechien & Slowakei / Česká republika & Slovensko
 Frankreich / France
Frankreich / France
 Deutschland / Deutschland
Deutschland / Deutschland
 Griechenland / ΕΛΛΑΔΑ
Griechenland / ΕΛΛΑΔΑ
 Ungarn / Hungary
Ungarn / Hungary
 Italien / Italia
Italien / Italia
 Niederlande / Nederland
Niederlande / Nederland
 Nordic / Nordic
Nordic / Nordic
 Polen / Polska
Polen / Polska
 Portugal / Portugal
Portugal / Portugal
 Rumänien & Moldawien / România & Moldova
Rumänien & Moldawien / România & Moldova
 Slowenien / Slovenija
Slowenien / Slovenija
 Serbien & Montenegro / Србија и Црна Гора
Serbien & Montenegro / Србија и Црна Гора
 Spanien / España
Spanien / España
 Schweiz / Schweiz
Schweiz / Schweiz
 Türkei / Türkiye
Türkei / Türkiye
 Großbritannien und Irland / UK & Ireland
Großbritannien und Irland / UK & Ireland
 International / International
International / International
 Brasilien / Brasil
Brasilien / Brasil
 Kanada / Canada
Kanada / Canada
 Lateinamerika / Latinoamérica
Lateinamerika / Latinoamérica
 USA / USA
USA / USA
 China / 中国
China / 中国
 Indien / भारत गणराज्य
Indien / भारत गणराज्य
 Pakistan / Pākistān
Pakistan / Pākistān
 Vietnam / Việt Nam
Vietnam / Việt Nam
 ASEAN / ASEAN
ASEAN / ASEAN
 Israel / מְדִינַת יִשְׂרָאֵל
Israel / מְדִינַת יִשְׂרָאֵל
 Algerien, Marokko und Tunesien / الجزائر والمغرب وتونس
Algerien, Marokko und Tunesien / الجزائر والمغرب وتونس
 Naher Osten / Middle East
Naher Osten / Middle East

To post a reply please login or register